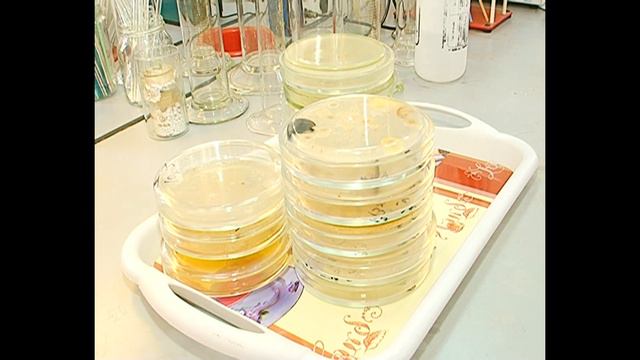
день науки   золото добывают из грибов

КРУТАЯ МУЗЫКА В МАШИНУ 🔊 BASS BOOSTED 🔊 ПОДБОРКА ЛУЧШИХ ТРЕКОВ 🔥 ПЛЕЙЛИСТ 🚨 Car Music Mix 🚨
Треклист
00:00 FanEOne - Lunatic
02:19 XZEEZ - Ploua (Remix)
06:53 Masked Wolf - Astronaut In The Ocean (Emre Kabak x Sercan Özkan Remix )
09:50 ⚠️САМЫЕ...
Смотреть